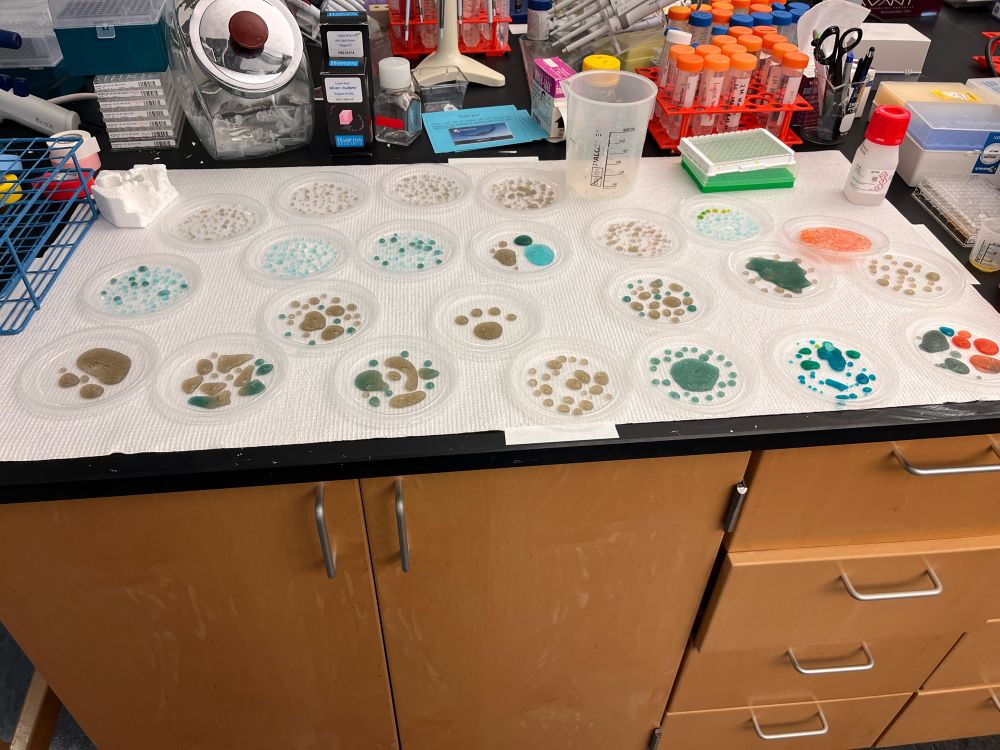

professional protein crystal whisperer, pipet tip chaos agent, buffalonian
views my own
#structuralbiology #crystallography #mycology

#structuralbiology #crystallography #mycology



#metalloprotein #biochemistry

#metalloprotein #biochemistry

#structuralbiology #crystallography
@blackinbiophys.bsky.social

#structuralbiology #crystallography
@blackinbiophys.bsky.social

Hey! I’m Gabby Budziszewski, PhD. I am a biochemist and structural biologist and am operations manager at the National Crystallization Center 💎 in Buffalo, NY.
Passionate about metalloproteins, equity in biomedical research, and foster kittens


Hey! I’m Gabby Budziszewski, PhD. I am a biochemist and structural biologist and am operations manager at the National Crystallization Center 💎 in Buffalo, NY.
Passionate about metalloproteins, equity in biomedical research, and foster kittens





